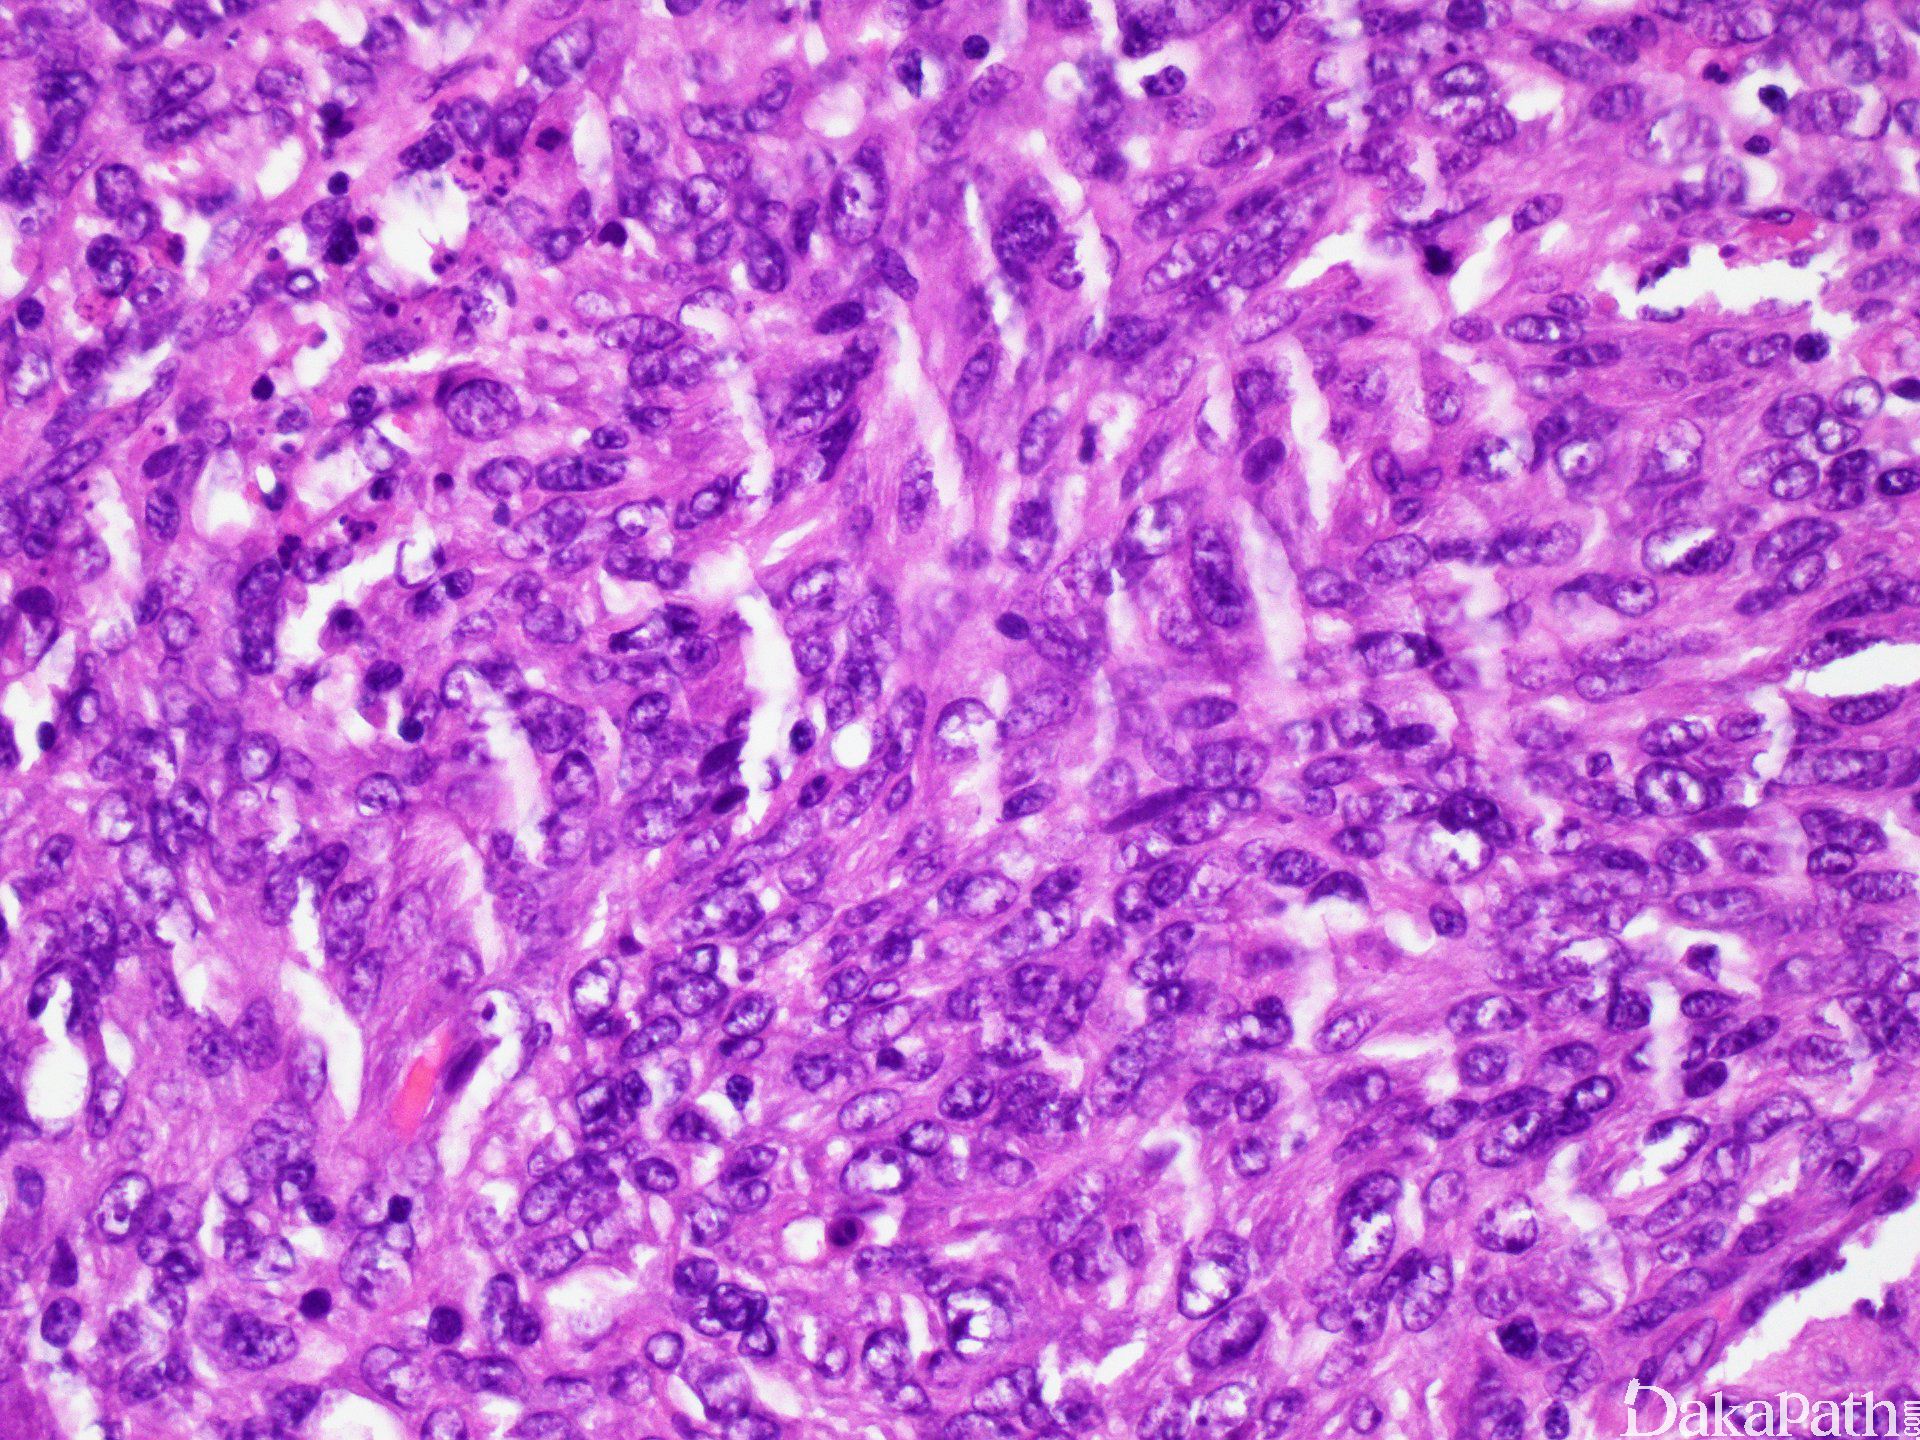

滤泡树突细胞肉瘤
Follicular Dendritic Cell Sarcoma, FDCS
概述:
FDCS 是一种由椭圆形或梭形细胞组成的肿瘤,在形态学和免疫学上具有滤泡树突细胞的特征。该类细胞正常情况下局限定居于淋巴结的滤泡。
诊断要点:
罕见,主要成人发病,中位年龄 50 岁。表现为淋巴结无痛性缓慢增大,最常累及颈部淋巴结,也可累及腋窝、纵隔、肠系膜等部位淋巴结;或表现为结外组织包快,累及部位包括扁桃体、口腔、胃肠道等。少数病例(10%)同时累及淋巴结和结外组织。
肿瘤细胞弥漫或结节状增生,呈现席纹样或漩涡状排列,细胞之间边界不清,背景混有小淋巴细胞。核分裂率 0 ~ 10/10HPF,但有的病例特别是复发病例,细胞具有显著多形性,核分裂像也明显增高,甚至有坏死。
细胞核形态卵圆形到梭形,核染色质呈空泡或颗粒状,核膜薄,核仁小但清晰。胞质嗜酸性,含量中等,略呈纤维细丝状,有时见多核巨细胞。此外,还有较少见的变异形态(见下)。
免疫组化:肿瘤细胞 CD21+、CD23+、CD35+,也常表达 clusterin、CXCL13. EGFR。 不表达 CD1a、Langerin、CD30. ALK。 不表达或有时不同程度表达 S100. CD68。
电镜可见大量桥粒和许多交织的长绒毛状突起,无 Birbeck 颗粒
有的病例有 Ig 基因克隆性重组,BRAF 突变也有报道。
变异型:
- 上皮样变异型:肿瘤细胞呈现黏附性生长,核圆形或卵圆形,胞质丰富,嗜酸性,类似上皮样细胞。表达典型的 FDC 抗原。
- 霍奇金亚型:部分肿瘤细胞类似 HRS,表达典型的 FDC 抗原。
- 炎性假瘤样亚型:此亚型几乎只原发于肝脾。形态类似炎性假瘤或炎性肌纤维母细胞瘤,表现为梭形细胞混合于炎性细胞中,甚至偶见 HR 样细胞。表达典型的 FDC 抗原,EBER+,但 ALK 阴性。
鉴别诊断:
- Langerhans 细胞组织细胞增生 /肉瘤(LCH/LCS):前者儿童多见,肿瘤细胞呈现典型的 Langerhans 细胞特征,有“咖啡豆样”核沟,无异常核分裂像。背景较多嗜酸性粒细胞。后者细胞有明显异型性,卵圆形,偶有复杂核沟。两者生长模式均不呈现席纹样或漩涡状,都表达 CD1a、S-100. Langerin,都不表达 CD21. CD23. CD35,电镜下都有 Birbeck 颗粒。
- 组织细胞肉瘤 :肿瘤细胞弥漫增生,细胞大,圆或椭圆形,胞质丰富嗜酸,染色质泡状,核膜可不规则。肿瘤细胞 CD68+、CD163+、CD21-、CD23-、CD35-。
- 交指状树突细胞肉瘤 (IDCS):肿瘤细胞为梭形或上皮样形态,车轮状或席纹状排列,形态学与 FDCS 相似。但肿瘤细胞表达 S100,不表达 CD21. CD23. CD35。
- 恶性黑色素瘤 :转移至淋巴结时,其细胞形态可类似 FDCS(特别是其上皮样亚型),但胞质内常含有褐色色素,有助诊断。肿瘤细胞 S100+、HMB45+、Melan A+,CD21. CD23. CD35 阴性。
- 间变大细胞淋巴瘤(ALCL, ALK+ /-) : 需与 FDCS(特别是其上皮样亚型)相鉴别。肿瘤细胞形态单一,几乎全是成片间变大细胞,并有“标志性”细胞。肿瘤细胞均匀一致强表达 CD30。EMA 和细胞毒分子也常阳性,T 细胞相关抗原阳性(如 CD4),部分病例 ALK 阳性(ALK+ ALCL)。 CD21. CD35. CD23 阴性。
- 炎性肌纤维母细胞瘤 (Inflammatory myofibroblastic tumor, IMT):主要需与 FDCS 的炎性假瘤样亚型相鉴别。IMT 不表达 CD21. CD23. CD35, 部分病例表达 ALK。
- 经典型霍奇金淋巴瘤(CHL) :需要与 FDCS 的霍奇金样亚型相鉴别。CHL 的背景有大量炎性细胞,肿瘤细胞(HRS)相对稀少,表达 CD30. CD15. PAX5,EBER+/-,不表达 CD21. CD23. CD35。
- 转移癌/胸腺癌 :淋巴结转移癌(特别是梭形细胞癌)和胸腺癌,细胞形态可类似 FDCS 或其上皮样亚型,但肿瘤细胞表达 CK,不表达 CD21. CD23. CD35。
预后:
局部手术切除(伴或不伴放、化疗)后,局部复发或远处转移率接近 1/3。